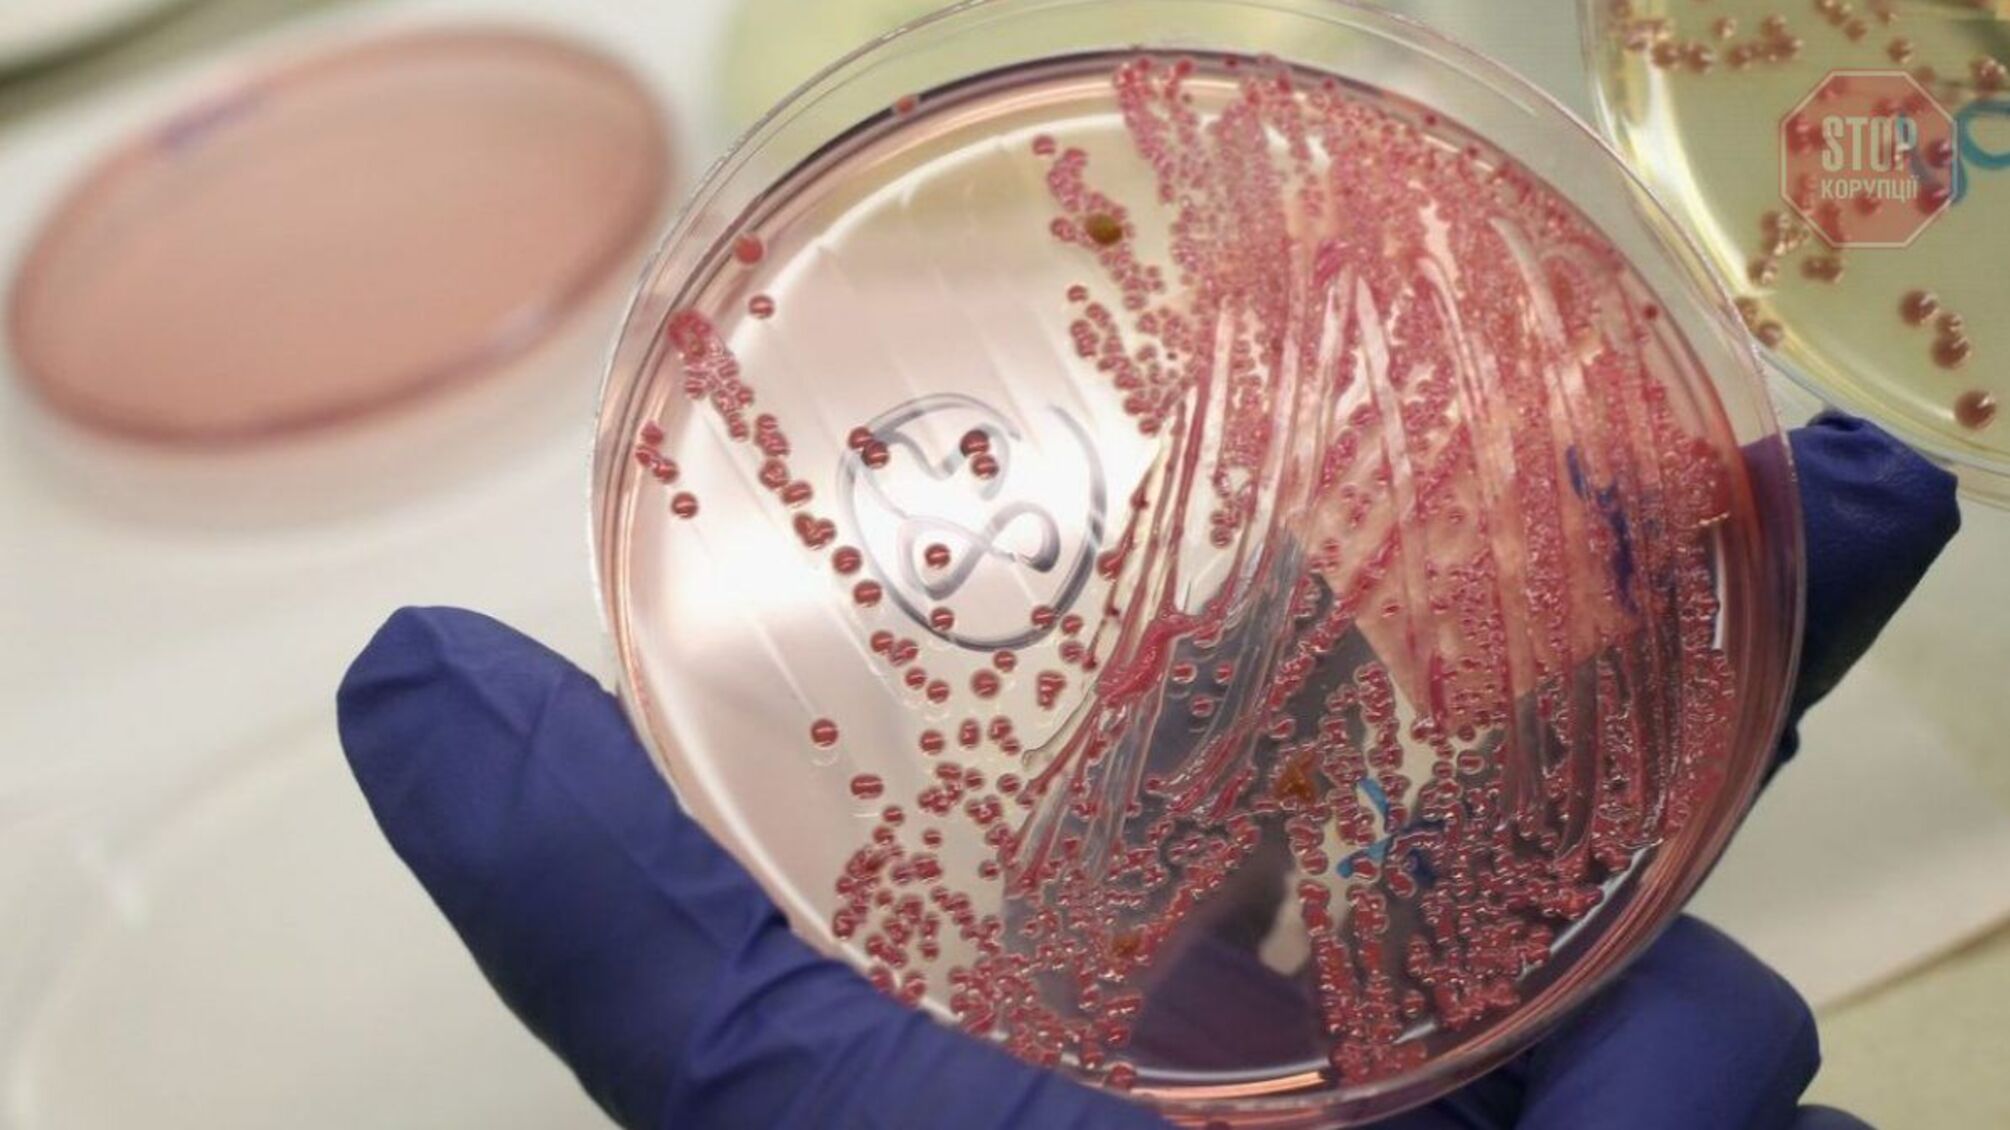
В Киевской области возникла угроза распространения сибирской язвы (видео)

Вместо спокойной жизни в тихом районе, угроза подхватить смертельную инфекцию. Элитный коттеджный городок в Киевской области строится возле бывшего захоронения животных с опасным заболеванием. Почему этот участок нельзя потрогать? И действительно ли существует угроза распространения сибирской язвы в регионе? Расследовала Александра Сербин.
Компания «Экобуд» строит коттеджный городок «Obriy Family Club» в Ходосовке Киевской области. Дома здесь можно приобрести от 700 тысяч долларов, и расположены они, согласно рекламе, в экологически чистом месте. Казалось бы, при чем здесь вероятное распространение сибирской язвы?
В руки «СтопКор» попал старый каталог захоронений для животных. Он свидетельствует, что в 1960-х годах на этой территории был устроен могильник для больных животных.

Могут ли строительные работы вызвать новую вспышку сибирской язвы?
«Если есть захоронение животных с сибирской язвой, эта территория вообще не подпадает под какую-либо разработку. Это место нельзя трогать. Если его затронуть, возможна вспышка сибирской язвы. Согласно нормам, имеется площадь в 1000 метров, которая считается санитарной зоной", – комментирует и.о. заместителя председателя Государственной службы Украины по безопасности пищевых продуктов и защите прав потребителей в Киевской области Роман Гаврилов.

Между тем врачи и биологи напоминают, что «сибирка» является особо опасным бактериальным заболеванием, которое может иметь фатальные последствия.
При этом риск заражения сохраняется в течение 100 лет.
«Это заболевание может принимать три формы. Самый простой из них – кожная. Смертность может достигать 20%. Легочная и кишечная формы намного тяжелее, человек может заразиться, вдыхая споры. Если заболевание вовремя не лечить, смерть наступает в 90% случаев», – поясняет кандидат биологических наук Евгения Яниш.
Стоит отметить, что по словам главы компании-застройщика «Экобуд» Павла Сомова, о присутствии скотомогильника вблизи будущего объекта он, якобы, знает только по слухам. А исследования, проведенные компанией, будто бы, не подтвердили эту информацию.


















